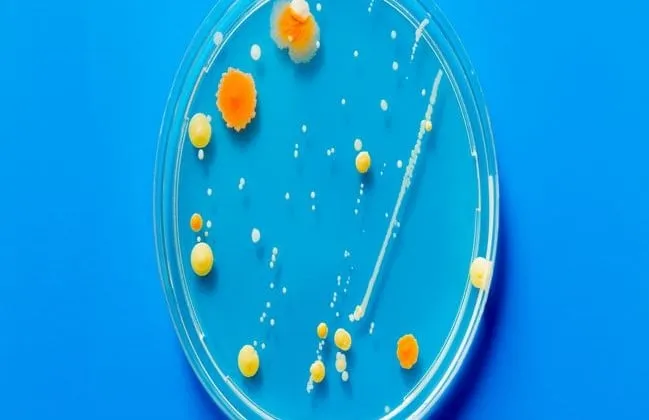
ndm bacterie

Bedrijfspand aan de Ronde Tocht een half jaar gesloten wegens hennepteelt
21 sep 2018, 19:52 • Actueel

Pixabay
Burgemeester Jan Hamming heeft vandaag een bedrijfspand aan de Ronde Tocht in Zaandam gesloten nadat daar een hennepkwekerij met 246 planten was aangetroffen.
Ook was er sprake van diefstal van stroom en water. Het pand blijft zes maanden dicht.
Loading articles...
Loading